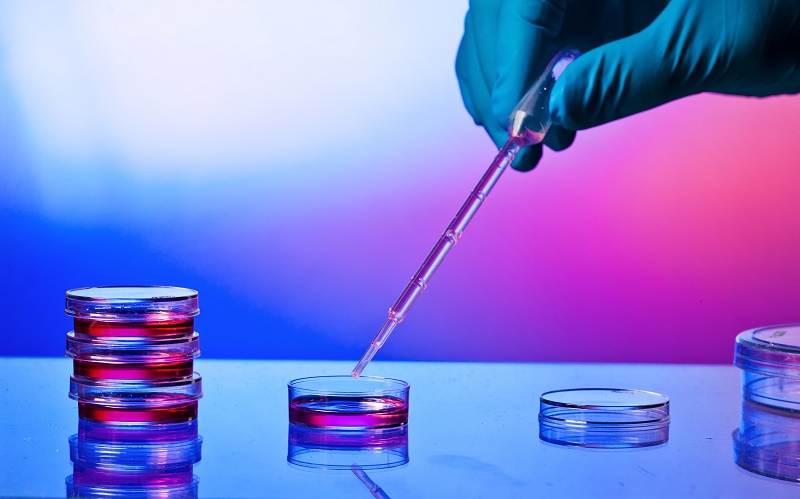

- Home
- News
- Pharma
- Opinion
-
Special
- Bio Special
- Union Budget 22
- Health science earning Survey
- Union Budget 2026-27
- Union Budget 2023-24
- Bioservices- June 2022 Survey
- Bioincubators- June 2022 Survey
- Biopharma- May 2022 Survey
- Diagnostic/ Medtech- April 2022 Survey
- Industrial enzymes- Feb 2022 Survey
- Biosuppliers- Jan 2022 Survey
- Job Seeker's Behaviour Survey
- Healthcare
- Start-ups
- Bio-Med
- Bio Interactions
- Suppliers
- States